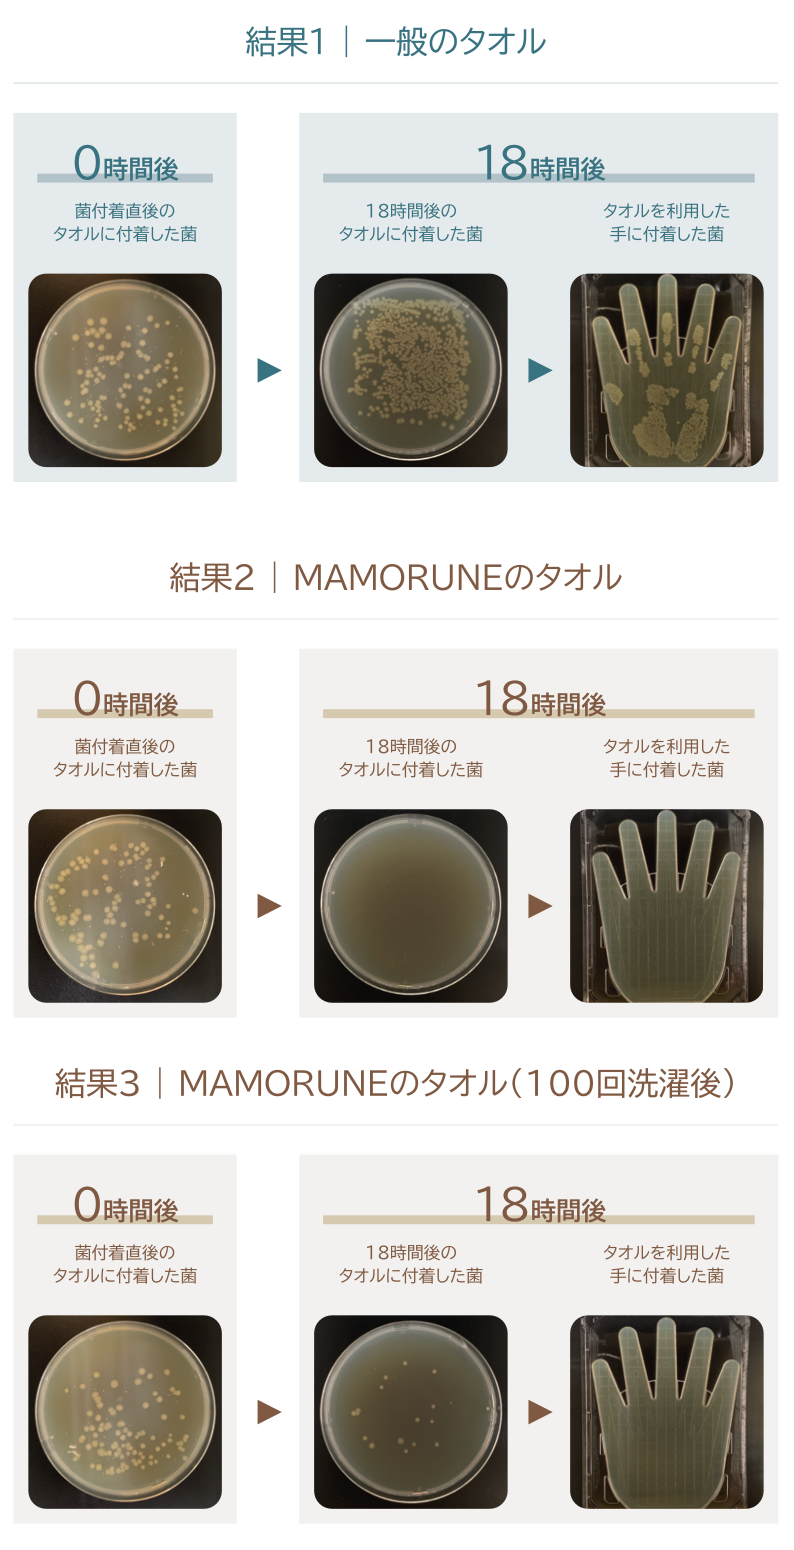

「菌もどり」とは
|菌もどりとは
一般的なタオルの場合、一度でも手や顔を拭くと、手や顔に付いていた菌がタオルに移り知らない間に増殖し続けていきます。
せっかくキレイに手を洗っても、そのタオルを利用すると増殖した菌が再び手や顔に戻ってしまう。これが「菌戻り」です。
|菌もどり試験結果
一般的なタオルと、高い抗菌機能を実現したMAMORUNEのタオルで実験を行いました。
タオルに菌を付着させ、18時間後に菌の数を計測。さらに、18時間経過したタオルを利用した手に菌がどれだけ付着しているかを比較しました。
※以下の写真は、実験結果の写真となります。実際のタオルを使用しているため、結果にはばらつきがあります。
※写真の菌は、タオルや手についた菌の数を比較するために菌を培養する培地にタオルや手をつけて、菌を転写し、培養後のものです。
※全ての菌の増殖を抑える、無菌状態を実現するわけではありません。
※写真の菌は、タオルや手についた菌の数を比較するために菌を培養する培地にタオルや手をつけて、菌を転写し、培養後のものです。
※全ての菌の増殖を抑える、無菌状態を実現するわけではありません。
|MAMORUNEなら菌戻りにも安心。
MAMORUNEのタオルは高い抗菌機能を実現。 タオルに付着した菌の増殖を減らすことで 菌戻りを抑えます。 抗菌機能は洗濯を100回繰り返しても 持続することができ、毎日の家族の暮らしを 守ることができます。
<試験方法>
「菌戻り」の試験にあたっては手洗い・消毒を行い手に菌が付着していない状態を確認。 その上で、菌付着後、18時間経過した一般のタオルとMAMORUNEのタオルを利用して 手を拭きました。その上で菌の数を把握するために培地に手をつけて、菌を転写し、培養後に比較を行いました。
「菌戻り」の試験にあたっては手洗い・消毒を行い手に菌が付着していない状態を確認。 その上で、菌付着後、18時間経過した一般のタオルとMAMORUNEのタオルを利用して 手を拭きました。その上で菌の数を把握するために培地に手をつけて、菌を転写し、培養後に比較を行いました。

<検査実施機関>
一般財団法人日本繊維製品品質技術センター 神戸試験センター
報告書No.22KB-070264にて実施。
一般財団法人日本繊維製品品質技術センター 神戸試験センター
報告書No.22KB-070264にて実施。